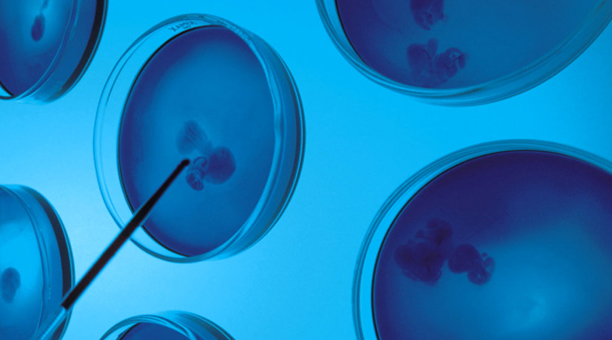
Itsas Natura Oiartzun

Itsas Natura Oiartzun
Actividad sin definir en Ugaldetxo
Asesoría integral higiénico-sanitario. APPCC, IFS.
Contacta con Itsas Natura
Si incluyes tu teléfono, el negocio te podrá llamar
Información y servicios de Itsas Natura
- Asesoría integral higiénico-sanitario. APPCC, IFS.
- Laboratorio ENAC. Microbiología, Nutricionales, Alérgenos .
- Formación. Cursos Manipulador de alimentos.
Actividades
ACTIVIDAD SIN DEFINIR
Acerca de Itsas Natura
ITSAS NATURA es una empresa dedicada a la asesoría integral higiénico-sanitaria ( la industria alimentaria, la restauración, las instalaciones deportivas o las piscinas comunitarias )
Contamos con un laboratorio acreditado por ENAC para análisis microbiológicos y físico-químicos de aguas y alimentos, un Departamento de Asesoría Técnica y un Área de Formación. Nuestro equipo lo integran biólogos, tecnólogos de alimentos, dietistas y analistas altamente cualificados para ofrecer el mejor servicio y satisfacer las necesidades de nuestros clientes.
Contamos con una amplia experiencia en este sector.
- Agua, alimentos, legionella, alérgenos.
- Aguas de consumo, aguas de baño y Legionella.
- Formación a empresas . Cursos de manipulador de alimentos.
- Análisis de glúten.
- Inmunoensayos y ADN.
- Superficies, ambiente y envases.
- Asesoría técnica:
Nuestro equipo asesor, formado por biólogos, licenciados en tecnología de alimentos
y diplomados en dietética y nutrición cuenta con más de 20 años de experiencia en la
implementación de Sistemas de Autocontrol APPCC, Plan Genérico de Autocontrol de
Hostelería, Sistemas de Gestión de Calidad-Seguridad Alimentaria Estándares IFS y
BRC, así como Q de Calidad.
Itsas Natura es una empresa que fue constituida el 03/04/1997 bajo la forma social de SOCIEDAD LIMITADA y cuyo CNAE (Clasificación Nacional de Actividades Económicas) se corresponde con la actividad: Otras actividades sanitarias. Cuenta actualmente con una plantilla de de 10 a 50. Su capital social es de 10.000€ - 50.000€. Actualmente, su facturación se encuentra en el rango de entre 500.000€ - 1.000.000€.
Información financiera y mercantil
- Fecha de constitución: 03/04/1997
- Forma social: SOCIEDAD LIMITADA
- Actividad CNAE: Otras actividades sanitarias
- Rango Nº empleados: de 10 a 50
- Rango de facturación: 500.000€ - 1.000.000€
- Rango del capital social: 10.000€ - 50.000€
Información adicional
- Itsas Natura forma parte de la red Beedigital y su información está verificada y protegida.
- Fecha de apertura: 1992
Encuentra en Páginas Amarillas toda la información y servicios sobre Itsas Natura. Consulta el teléfono de contacto y la dirección en Ugaldetxo para saber cómo llegar.
Infórmate del horario de apertura y cierre. Visualiza el negocio a través de sus fotos y vídeos.
Encuentra también opiniones de otros usuarios sobre Itsas Natura.

%%-pros-%%
%%-cons-%%